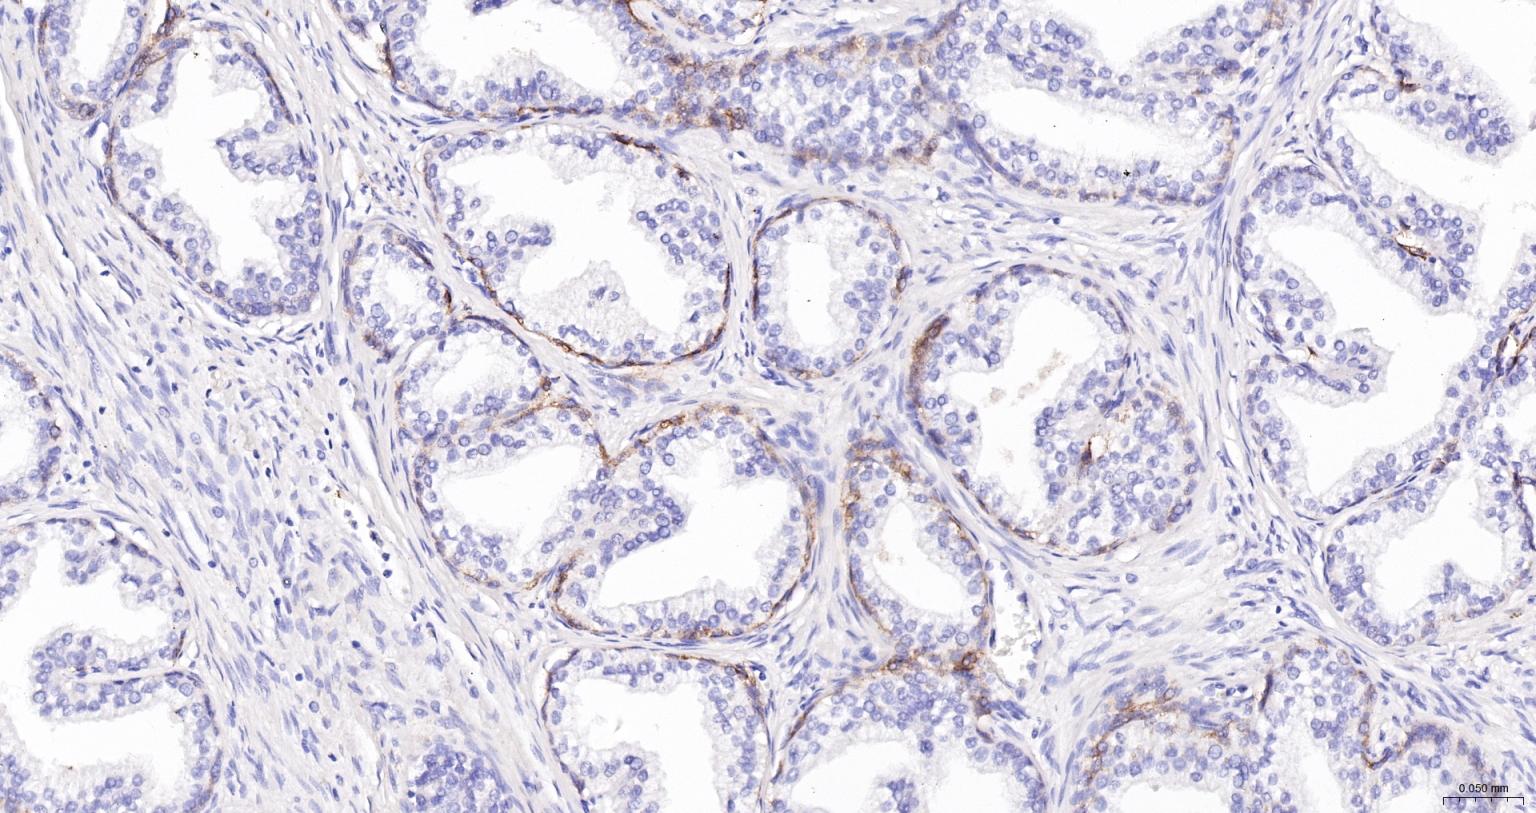
神经生长因子受体重组兔单抗

NGFR | p75NTR Recombinant Rabbit mAb (一抗) - IHC-P,IHC-F,IF | Bioss
Rrmab?兔单抗

货号:bsm-43637R
产品详情
相关标记
相关产品
相关文献
常见问题
概述
产品编号
bsm-43637R
产品类型
重组兔单抗
英文名称
NGFR | p75NTR Recombinant Rabbit mAb
中文名称
神经生长因子受体重组兔单抗
英文别名
CD271; Gp80-LNGFR; TNFRSF16; p75(NTR); p75NTR; LNGFR; p75; p75NGFR; RNNGFRR; TNR16_HUMAN; NGFR; Low affinity neurotrophin receptor p75NTR; Low-affinity nerve growth factor receptor (NGF receptor); Low-affinity nerve growth factor receptor p75NGFR; Low-affinity nerve growth factor receptor p75NGR; p75 ICD; TNR16_MOUSE; TNR16_RAT;
抗体来源
Rabbit
免疫原
Recombinant human NGFR protein: 29-250/427
亚型
IgG
性状
Liquid
纯化方法
affinity purified by Protein A
克隆类型
Recombinant
克隆号
7G1
理论分子量
44 kDa
浓度
1mg/ml
储存液
0.01M TBS (pH7.4) with 1% BSA, 0.02% Proclin300 and 50% Glycerol.
研究领域
SWISS
Gene ID
保存条件
Shipped at 4℃. Store at -20℃ for one year. Avoid repeated freeze/thaw cycles.
注意事项
This product as supplied is intended for research use only, not for use in human, therapeutic or diagnostic applications.
数据库链接
产品介绍
神经生物学相关蛋白(Neurobiology)
NGFR神经生长因子受体又称:CD271存在与细胞上的与神经生长因子相结合并相互作用的蛋白质因子,属一型跨膜TNF受体超家族糖蛋白,它可与NGF, BDNF, NT-3, NT-4 结合,根据与神经生长因子的结合力速度及亲和力可分为高亲和力和低亲和力两种NGFR。
此抗体识别分子量为47kDa低亲和力的NGFR.NGF-R也称为低亲和神经生长因子受体,属1型跨膜TNF受体超家族。
NGFR神经生长因子受体又称:CD271存在与细胞上的与神经生长因子相结合并相互作用的蛋白质因子,属一型跨膜TNF受体超家族糖蛋白,它可与NGF, BDNF, NT-3, NT-4 结合,根据与神经生长因子的结合力速度及亲和力可分为高亲和力和低亲和力两种NGFR。
此抗体识别分子量为47kDa低亲和力的NGFR.NGF-R也称为低亲和神经生长因子受体,属1型跨膜TNF受体超家族。
背景资料
The low affinity NGFR (Nerve growth factor receptor) is a 75kDa membrane-spanning glycoprotein lacking intrinsic tyrosine kinase activity. p75NGFR interacts with TrkA, the high affinity NGF receptor and potentiates TrkA signaling at low NGF concentrations. The p75 receptor binds nerve growth factor, brain-derived neurotrophic factor, neurotrophin-3 and neurotrophin-4 with varying specificities. The p75NGFR plays an important role in neurotrophic factor signaling and has been shown to modulate the susceptibility of selective cellular populations to programmed cell death. It is expressed on many neuronal cells types including many embryonic forms and the receptor can be used to isolate neuronal progenitor cells. NGF is important for the development, differentiation and survival of a variety of neuronal and non-neuronal cells. Its action is mediated by binding to two distinct receptors, the high affinity p140 and low affinity p75. p75NGFR binds neurotrophins including brain-derived neurotrophic factor (BDNF), neurotrophin-3 (NT-3), NT-4/5, and NT-6. p75NGFR belongs to the TNF-R superfamily and is reported to mediate NGF-induced apoptosis.

产品应用
| 应用 | 已检合格种属 | 预测种属 | 推荐稀释比例 |
|---|---|---|---|
| IHC-P | Human | 1:100-500 | |
| IHC-F | Human | 1:100-500 | |
| IF | Human | 1:100-500 |
交叉反应
交叉反应: Human
相关产品
暂无相关产品
靶标
基因名
NGFR
蛋白名
Tumor necrosis factor receptor superfamily member 16
亚基
Homodimer; disulfide-linked. Interacts with p75NTR-associated cell death executor. Interacts with NGFRAP1/BEX3. Interacts with TRAF2, TRAF4, TRAF6, PTPN13 and RANBP9. Interacts through TRAF6 with SQSTM1 which bridges NGFR to NTRK1. Interacts with BEX1. Interacts with KIDINS220 and NTRK1. Can form a ternary complex with NTRK1 and KIDINS220 and this complex is affected by the expression levels of KIDINS220. An increase in KIDINS220 expression leads to a decreased association of NGFR and NTRK1. Interacts with LINGO1 (By similarity). Interacts with NTRK2; may regulate the ligand specificity of the NTRK2 receptor. Interacts with NRADD.
亚细胞定位
Membrane; Single-pass type I membrane protein.
翻译后修饰
N- and O-glycosylated.
Phosphorylated on serine residues.
Phosphorylated on serine residues.
相似性
Contains 1 death domain.
Contains 4 TNFR-Cys repeats.
Contains 4 TNFR-Cys repeats.
功能
Low affinity receptor which can bind to NGF, BDNF, NT-3, and NT-4. Can mediate cell survival as well as cell death of neural cells.
同靶标产品
相关文献
提示: 发表研究结果有使用 bsm-43637R 时请让我们知道,以便我们可以引用参考文章。作为回馈,资料提供者将获得我们送上的小礼品。